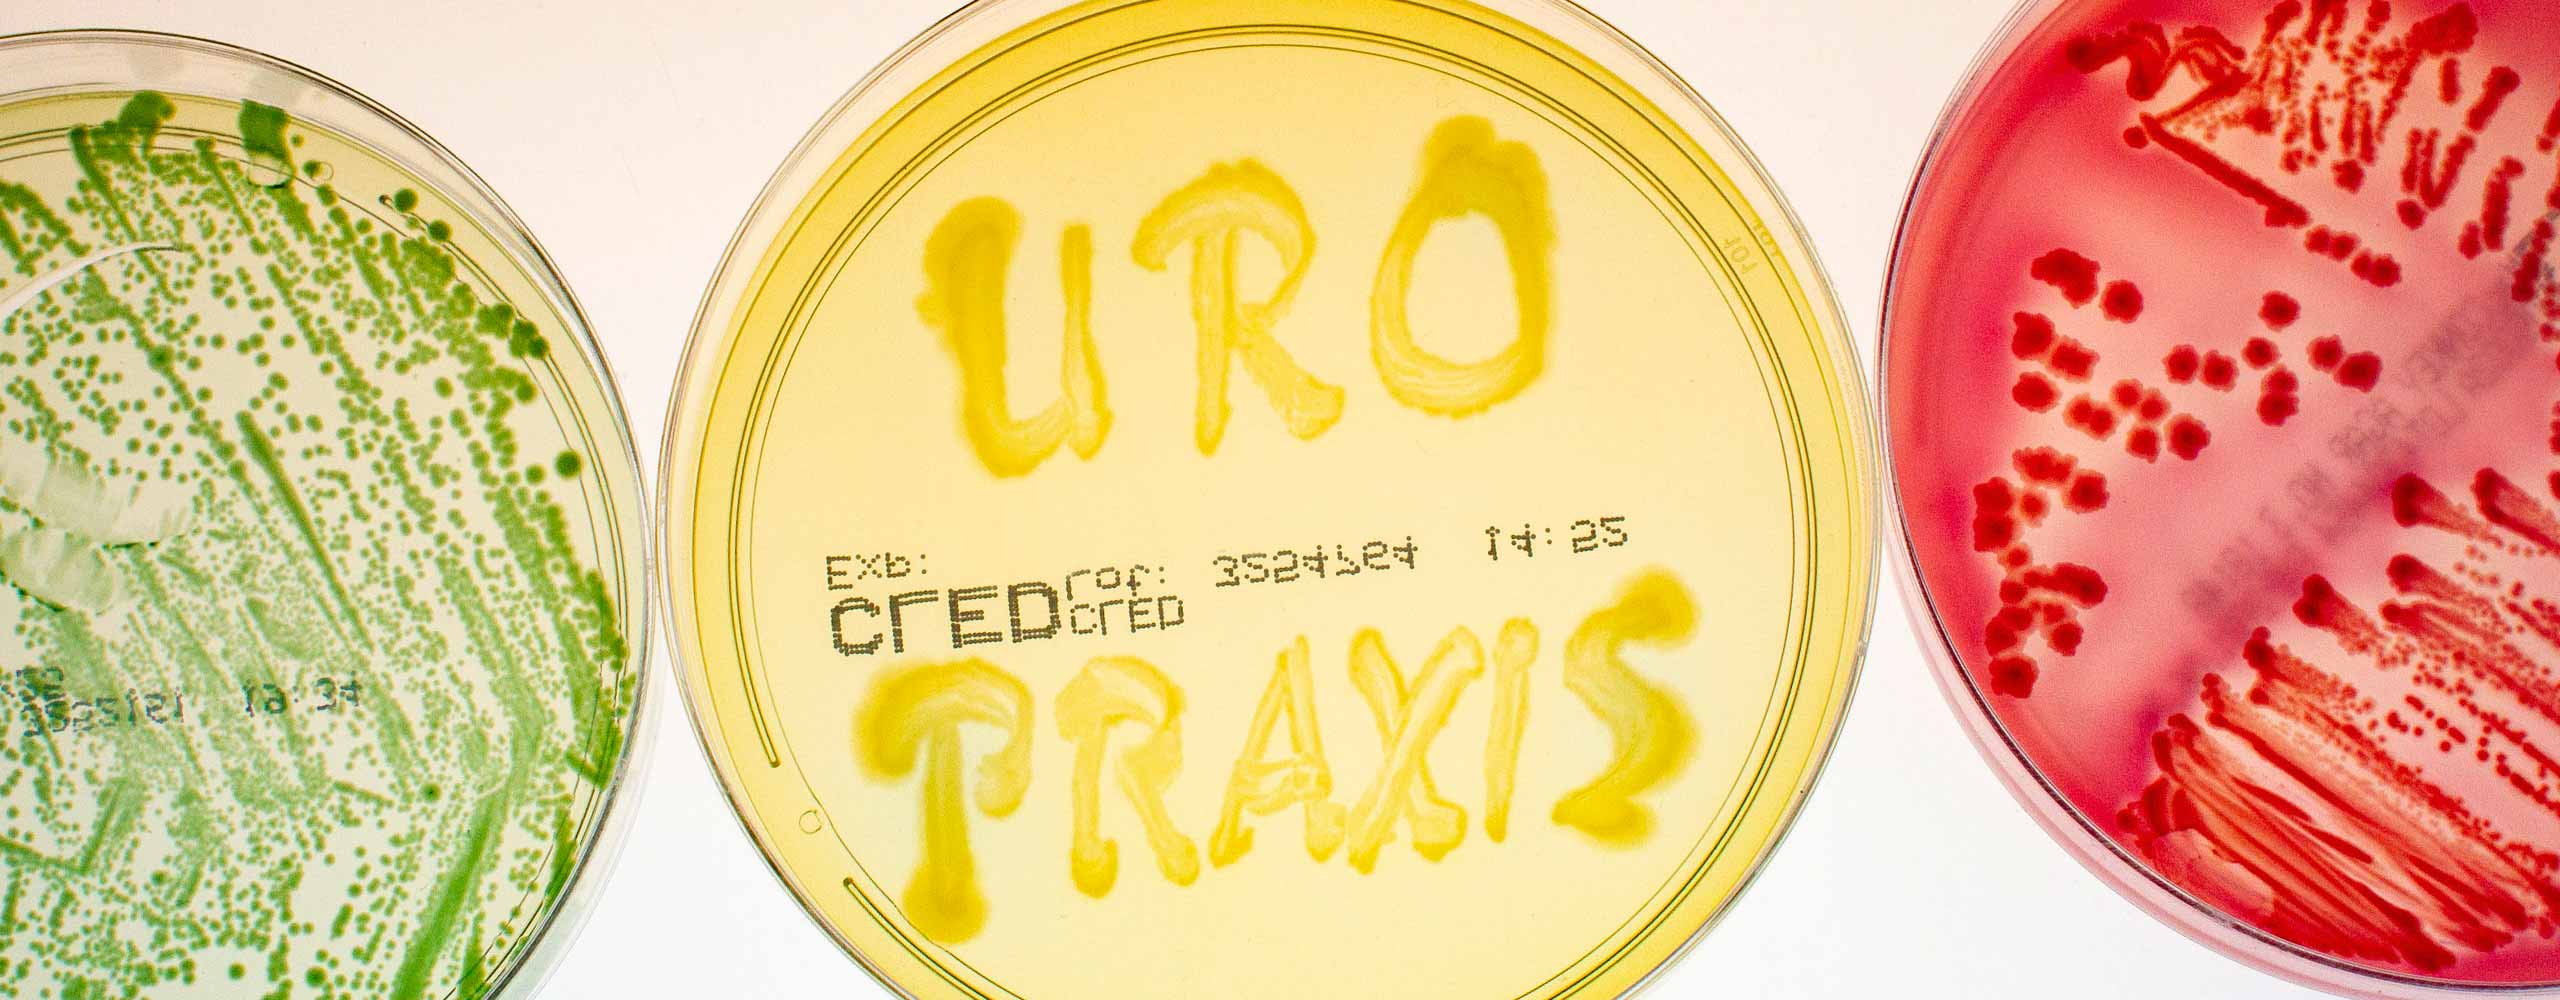

Ihr Urologe in Buchen
Herzlich Willkommen auf der Webseite der Urologischen Praxis in 74722 Buchen (Odenwald)!
Hier bieten wir Ihnen die Möglichkeit, sich über unsere Urologie-Praxis und unser Leistungsangebot einen Überblick zu verschaffen. In unserer urologischen Praxis in Buchen, im Ärztehaus direkt bei den Neckar-Odenwald-Kliniken in Buchen behandeln wir privat und gesetzliche PatientInnen.
Urologische Praxis Dr. med Peter Breitling
In unserer Urologie-Praxis in Buchen betreiben wir ein eigenes mikrobiologisches und andrologisches Labor. Hier führen wir chemische, mikroskopische und zytologische Urinuntersuchungen durch, identifizieren Krankheitserreger im Urin und führen Empfindlichkeitstests geeigneter Antibiotika, Krebsvorsorgetests.
Ferner verfügt die Praxis über einen endoskopischen Behandlungsraum sowie vier Untersuchungszimmer, die mit modernen Ultraschallgeräten mit Farbduplexeinheit und dreidimensionaler Darstellbarkeit der Organe ausgestattet sind. Hierdurch kann in der Praxis nahezu das gesamte diagnostische Spektrum der Urologie vor Ort angeboten werden.
Im praxiseigenen Eingriffsraum werden ambulante Eingriffe wie Prostatastanzbiopsien, BOTOX-Injektionen und auch Vasektomien (Sterilisationsoperationen) in Lokalanästhesie durchgeführt. Vasektomien werden auf Wunsch auch im ambulanten OP-Zentrum Wertheim angeboten. Dr. med. Peter Breitling ist mit seiner urologischen Praxis in Buchen Mitglied im Netzwerk der Vasektomie-Experten.